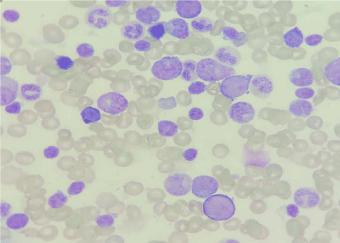
Article image

Recently Published Articles

Systematic Review | Open Access
Published on: 27 May 2026
Article ID: wjh.2026.e2704
Association of Haematological and Haemostatic Parameters with Female Reproductive Hormones: A Systematic Review and Research Synthesis of Mechanisms, Clinical Correlations, and Implications for Practice
Background: Female reproductive hormones exert systemic effects extending beyond reproductive physiology to influence hematopoiesis, immune regulation, endothelial integrity, and haemostatic balance. Cyclical and life‑stage hormonal variations significantly alter haematological and coagulation parameters.
Objective: To systematically review and synthesize evidence on the association between female reproductive hormones and haematological and…


Mini Review | Open Access
Published on: 09 Mar 2026
Article ID: wjh.2026.c0902
Monoclonal Gammopathy of Renal Significance (MGRS): Bridging the Gap Between Hematology and Nephrology
Monoclonal Gammopathy of Renal Significance (MGRS) is a clinical entity characterized by renal damage caused by monoclonal proteins secreted by clonal plasma or B-cell proliferative disorders, without meeting criteria for overt hematologic malignancies like multiple myeloma or lymphoma. From a hematologist's viewpoint, early identification of the underlying clone is crucial for guiding targeted therapy to preserve renal function.
MGRS lesions are classified into organized…


Case Report | Open Access
Published on: 02 Mar 2026
Article ID: wjh.2026.c0204
Hb M- Hyde Park - Rare Hemoglobinopathy in Tamil Nadu
Cyanosis is most often due to cardiac or pulmonary disease, but genetic and acquired disorders of hemoglobin can result in significant arterial desaturation. Disorders such as methemoglobinemia, sulfhemoglobinemia, Hemoglobin M, Low oxygen affinity hemoglobin are the differential diagnosis once cardiopulmonary causes were excluded [1]. Acquired disorders are more common whereas long standing symptoms or symptoms in siblings is suggestive of hereditary causes. A 23-year-old female patient…


Case Report | Open Access
Published on: 19 Feb 2026
Article ID: wjh.2026.b1904
Giant Spontaneous Inferior Epigastric Artery Rectus Sheath Hematoma
A spontaneous inferior epigastric artery rectus sheath hematoma is a rare condition where bleeding occurs within the sheath of the rectus abdominis muscle, often due to damage to the inferior epigastric artery or its branches. We present an adult case of giant spontaneous left inferior epigastric artery rectus sheath hematoma with dramatic life-threatening acute abdominal emergency which was managed successfully by conservative management.
Keywords: Acute Abdomen;…


Mini Review | Open Access
Published on: 17 Jan 2026
Article ID: wjh.2026.a1707
Gastrointestinal Parasites of Sheep and Goat and Their Contro
In small ruminants, particularly goats and sheep, gastrointestinal (GI) parasites have led to serious socioeconomic and public health issues on a global scale. Goats and sheep can contract gastrointestinal parasites from helminths and protozoa, with nematodes and coccidian being the most prevalent. Parasite illnesses kill hundreds of thousands of livestock severely affecting the development of agriculture & poverty alleviation in emerging countries. Improving small ruminants’ health requires…

Case Report | Open Access
Published on: 31 Dec 2025
Article ID: wjh.2025.l3103
Pure Red Cell Aplasia with Overlapping Hemolytic Anemia in a Term Neonate: A Case Report
Pure Red Cell Aplasia (PRCA) is an infrequent hematological disorder marked by profound inhibition of erythroid production with preservation of other marrow cell lines. Its occurrence during the neonatal period is rare and often leads to delayed recognition. We describe a term neonate who presented with progressive pallor and severe anemia during the second week of life. Hematological evaluation revealed persistent normocytic normochromic anemia with marked reticulocytopenia. Bone marrow…


Research Article | Open Access
Published on: 19 Sep 2025
Article ID: wjh.2025.i1902
Therapeutic Potential of CRISPR-Cas9 in Treating Inherited Hematological Disorders
Inherited hematological disorders, to a degree, weapon cell affliction, thalassemia, and hemophilia, have long been a challenge in clinical care, accompanying restricted therapeutic alternatives. These disorders are caused by ancestral mutations that hinder the function of blood cells, leading to lifelong obstacles. Traditional situations, containing blood transfusions and bone marrow transplants, offer only temporary relaxation and are frequently associated with significant risks. Recent…


 DOI: 10.5281/zenodo.20519825 »
DOI: 10.5281/zenodo.20519825 »